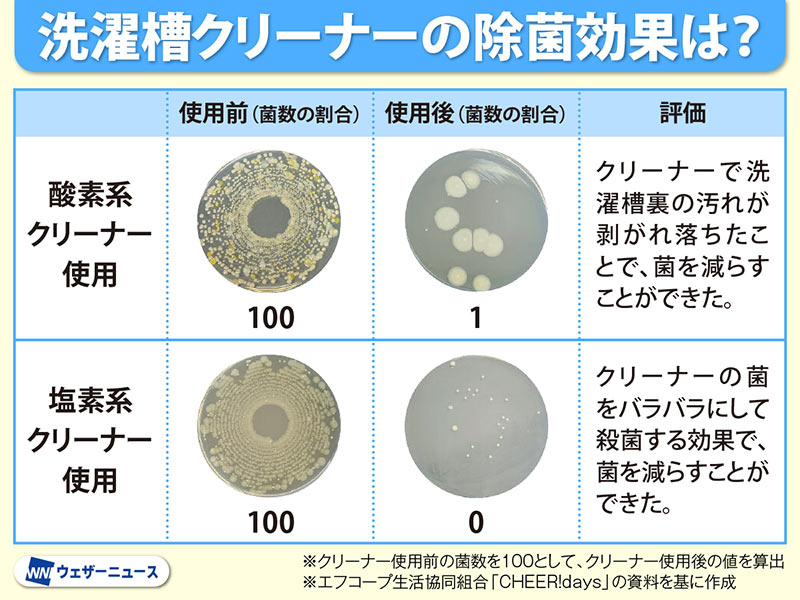

梅雨時に気になる洗濯槽の菌やカビ 洗濯槽クリーナーの効果は?
洗濯槽には見えない汚れがついている
洗濯物はきちんと干し上がっているのに生乾き臭がする場合、洗濯槽の汚れが臭いの原因となっていることがあります。
「洗濯槽の汚れがどのくらいついているのか、一般家庭の30台の洗濯機を対象に調査してみました。その結果、洗濯機の83%の洗濯槽から一般生菌(気温35℃前後、酸素があれば生育する細菌)やカビが検出されました。
使用して1年未満でも検出されていることから、使用年数、型式にかかわらず洗濯槽は菌とカビが繁殖しやすい環境にあると言えそうです。
この菌やカビで汚れた洗濯槽で洗濯すると、その汚れが洗濯物に付着し、室内干しなどの湿気た状態が続くと、菌やカビが増殖して臭いの原因になると考えられます」(光安さん)
調査結果から、臭いの原因は洗濯槽の汚れということがわかりました。
「洗濯槽の汚れがどのくらいついているのか、一般家庭の30台の洗濯機を対象に調査してみました。その結果、洗濯機の83%の洗濯槽から一般生菌(気温35℃前後、酸素があれば生育する細菌)やカビが検出されました。
使用して1年未満でも検出されていることから、使用年数、型式にかかわらず洗濯槽は菌とカビが繁殖しやすい環境にあると言えそうです。
この菌やカビで汚れた洗濯槽で洗濯すると、その汚れが洗濯物に付着し、室内干しなどの湿気た状態が続くと、菌やカビが増殖して臭いの原因になると考えられます」(光安さん)
調査結果から、臭いの原因は洗濯槽の汚れということがわかりました。
洗濯槽クリーナーの汚れ除去効果を調査
「洗濯槽の汚れを落とすには、洗濯槽クリーナーを使うのが一般的だと思います。そこでクリーナーで、どこまで汚れの素となる菌やカビが除去できるか調査しました。
市販されている洗濯槽クリーナーには『酸素系クリーナー』と『塩素系クリーナー』がありますので、この2種類で検証しています」(光安さん)
【調査方法】
菌とカビが検出された3台の洗濯機の洗濯槽を、酸素系クリーナーと塩素系クリーナーを使って説明書通りに洗浄。洗浄前後の菌数を調査
市販されている洗濯槽クリーナーには『酸素系クリーナー』と『塩素系クリーナー』がありますので、この2種類で検証しています」(光安さん)
【調査方法】
菌とカビが検出された3台の洗濯機の洗濯槽を、酸素系クリーナーと塩素系クリーナーを使って説明書通りに洗浄。洗浄前後の菌数を調査
「酸素系クリーナーは発泡した泡で汚れをはがして落とす効果があり、塩素系クリーナーは菌やカビをバラバラにして殺菌する効果があります。
結果的にどちらのクリーナーでも菌やカビを大幅に除去されることがわかりました。これにより臭いの原因も取り除くことができたと考えられます。
洗濯槽の汚れはあまり目立たない場合もありますが、菌やカビが発生しやすい梅雨時は塩素系で1~2ヵ月ごとに殺菌し、大掃除の際には酸素系で汚れをはがしてきれいにするという使い方で、洗濯槽は常に清潔な状態を保つのが重要です。
また、洗濯機の中に汚れ物を入れっぱなしにすると、その汚れ物が菌やカビの繁殖の原因となります。洗濯機を洗濯カゴ代わりにするのではなく、汚れ物は洗濯カゴに入れておいて、洗濯機は常にカラの状態にしておきましょう」(光安さん)
洗濯槽を常に清潔に保つことが嫌な臭いの原因となっていることがよくわかりました。洗い上がりが気持ちよくなるように心がけましょう。
» ウェザーニュースアプリ お洗濯情報
» お天気ニュース記事をアプリで見る» お天気ニュース記事一覧
結果的にどちらのクリーナーでも菌やカビを大幅に除去されることがわかりました。これにより臭いの原因も取り除くことができたと考えられます。
洗濯槽の汚れはあまり目立たない場合もありますが、菌やカビが発生しやすい梅雨時は塩素系で1~2ヵ月ごとに殺菌し、大掃除の際には酸素系で汚れをはがしてきれいにするという使い方で、洗濯槽は常に清潔な状態を保つのが重要です。
また、洗濯機の中に汚れ物を入れっぱなしにすると、その汚れ物が菌やカビの繁殖の原因となります。洗濯機を洗濯カゴ代わりにするのではなく、汚れ物は洗濯カゴに入れておいて、洗濯機は常にカラの状態にしておきましょう」(光安さん)
洗濯槽を常に清潔に保つことが嫌な臭いの原因となっていることがよくわかりました。洗い上がりが気持ちよくなるように心がけましょう。
» ウェザーニュースアプリ お洗濯情報
» お天気ニュース記事をアプリで見る» お天気ニュース記事一覧
お天気ニュース
各エリアの天気予報
アクセスランキング
アメダスランキング
気温
降水量
風
降雪量
湿度
順位
地点
観測値
警報・注意報の履歴
お天気ニュース
- 天気メニュー
- レーダーコンテンツ
- 防災・減災メニュー
- 自然・季節・レジャー情報
- 便利なメニュー